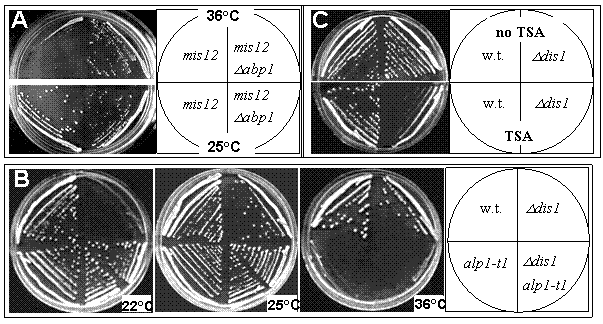

На правах рукописи
ФЕДЯНИНА Ольга Сергеевна
Исследование роли тубулинового кофактора D митозе у делящихся дрожжей Schizosaccharomyces pombe
03.00.03 – молекулярная биология
Автореферат
диссертации на соискание ученой степени
кандидата биологических наук
Москва
2008
Работа выполнена в Государственном учреждении
Гематологический Научный Центр Российской Академии Медицинских Наук.
Научный руководитель:
доктор биологических наук, профессор
Гематологический Научный Центр РАМН
Официальные оппоненты:
доктор биологических наук, профессор
»
кандидат биологических наук,
Гематологический Научный Центр РАМН
Bедущая организация: Институт общей генетики имени РАН
Защита диссертации состоится « » 2008 года
на заседании Диссертационного совета Д 217.013.01 при ФГУП
«Государственный научно-исследовательский институт генетики и селекции промышленных микроорганизмов»
г. Москва, 1-й Дорожный проезд, д.1
С диссертацией можно ознакомиться в библиотеке »
Автореферат разослан « » 2008 года
Ученый секретарь
диссертационного совета,
кандидат биологических наук
ВВЕДЕНИЕ
Актуальность темы. Понимание механизмов клеточного деления - это одна из важнейших задач современных биомедицинских исследований. Одной из ключевых фаз клеточного цикла является митоз. В процессе митоза происходит разделение генетической информации. Это осуществляется путем конденсации хроматина, “созревания” кинетохоров и образования веретена деления из микротрубочек. Взаимодействие микротрубочек с кинетохорами обеспечивает правильное закрепление и сегрегацию хромосом в процессе митоза. Неправильная сегрегация хромосом может привести к возникновению тяжелых заболеваний или гибели. Поэтому во время клеточного деления процесс сегрегации хромосом тщательно контролируется системой митотического контроля, называемой чекпойнтом веретена деления. Функция этой системы заключается в задерживании стадии расхождения хромосом до тех пор, пока все хромосомы не будут правильным образом прикреплены к микротрубочкам и биориентированы относительно полюсов деления. Микротрубочки являются важнейшим компонентом цитоскелета эукариотических клеток. Они участвуют в поддержании формы клетки, в транспорте органелл и становятся жизненно необходимы в митозе. Именно поэтому они являются одними из главных мишеней для противоопухолевых препаратов. Микротрубочки это динамичные биополимеры, состоящие из ab-гетеродимеров тубулина. Повышение уровня свободного a - и b-тубулина токсично для клеток и жестко регулируется (Cleveland et al. 1981). В формировании ab-гетеродимеров тубулина участвует пять кофакторов: A, B, C, D, E (Szymanski 2002). Кофакторы сборки тубулиновых ab-гетеродимеров это эволюционно консервативные белки у эукариот от дрожжей до человека (Lewis et al. 1997; Szymanski 2002). Было показано, что мутации в гене, кодирующем кофактор E, который является партнером кофактора D в пути сборки тубулиновых димеров, приводит к возникновению у человека тяжелых синдромов, приводящих к гипопаротироидизму, задержке умственного развития и лицевому дисморфизму (Parvari et al. 2002). Эти заболевания вызваны нарушениями димеризации тубулина и недостатком микротрубочек. Лучше всего биохимический путь формирования димеров изучен in vitro на выделенных белках быка (Tian et al. 1996; Tian et al. 1997; Tian et al. 1999). Кофакторы действуют на финальном этапе образования третичной структуры a - и b-тубулинов, способствуя формированию собственно ab-гетеродимера. Кофакторы B и A связываются с a - и b-тубулином соответственно (Tian et al. 1996), затем они передают a - и b-тубулины кофакторам E и D (Tian et al. 1997) соответственно, которые вместе с тубулинами образуют тетрамерный комплекс. Присоединение кофактора С и последующий гидролиз ГТФ завершают сборку димера (Tian et al. 1999).
Изучение пути свертывания тубулиновых димеров у различных организмов показало, что есть вариации в работе этого пути. Например, у делящихся дрожжей Schizosaccharomyces pombe (S. pombe), как и у высших эукариот, кофакторы жизненно необходимы для сборки тубулиновых димеров. А у почкующихся дрожжей Saccharomyces cerevisiae (S. cerevisiae) путь сборки тубулиновых димеров не является жизненно необходимым и это указывает на то, что пути формирования димеров у высших эукариот и у делящихся дрожжей S. pombe имеют больше общего, чем у S. cerevisiae. Основным отличием пути формирования у делящихся дрожжей S. pombe от высших эукариот является ведущая роль кофактора D в сворачивании тубулиновых димеров (Radcliffe et al. 1999). Достоинством делящихся дрожжей, как объекта исследования, является простота различных генетических манипуляций, в отличие от клеток высших эукариот. Хотя у S. pombe путь формирования димеров жизненно необходим, однако были получены мутации в генах, кодирующих кофакторы сборки тубулиновых димеров, приводящие к температурочувствительности клеток: клетки с такими мутациями жизнеспособны в определенном диапазоне температур и не жизнеспособны либо при повышении (температурная чувствительность), либо при понижении (холодочувствительность) температуры. Подобные мутации в генах, кодирующих кофакторы, приводят к исчезновению микротрубочек в клетках при росте на запрещающей температуре (Grishchuk and McIntosh 1999; Hirata et al 1998; Radcliffe et al.1999; Radcliffe et al. 2000a). Есть основания думать, что тубулин-свертывающие кофакторы помимо сворачивания димеров, обладают и рядом других функций в клетке. Так было показано, что кофакторы D, E и В в клетках животных при переизбытке обладают способностью разрушать димеры тубулина (Kortazar et al. 2006, 2007). Также, температурочувствительная мутация alp1-t1 в гене, кодирующем кофактор D у S. pombe, генетически взаимодействует с мутациями в генах, кодирующих компоненты Комплекса Инициирующего Анафазу и протеасомы (Grishchuk et al. 1998). Мутации в генах, кодирующих кофакторы, приводят к разрушениям структур микротрубочек, что впоследствии приводит к неправильному делению клетки. Однако какие стадии митоза нарушаются при отсутствии функции кофакторов до настоящего времени не было известно. Этот вопрос являлся целью данной работы.
Цель и задачи исследования. Настоящая работа делалась с целью выявить возможную роль кофактора D, участвующего в формировании нативной конформации тубулинового димера, в митозе.
Достижение указанной цели было связано с решением следующих задач:
1. Определить частоту возникновения дефектов сегрегации хромосом в клетках S. pombe с мутациями кофактора D при помощи минихросомы, и определить, зависит ли она от условий роста клеток и функционального состояния кинетохорных комплексов.
2. С помощью генетических методов определить возможных “партнеров” кофактора D в клетке среди белков кинетохорного комплекса.
3. С помощью методов флуоресцентной микроскопии определить какие митотические процессы нарушены в клетках с мутациями кофактора D.
4. Исследовать причины, приводящие к медленному развитию митотических нарушений в клетках с мутациями, используя различные методы синхронизации клеточного цикла.
Научная новизна. В работе показано, что клетки с мутациями кофактора D alp1-1315 и alp1-t1 имеют повышенную частоту потери минихромосомы. Мутанты кофактора D генетически взаимодействует с компонентами кинетохора Dis1, Mad2, Mph1, Abp1, что предполагает существенную роль кофактора D в установлении оптимального соединения кинетохора с микротрубочкой. Оба мутанта кофактора D имеют дефекты в прохождении метафазы. Также показано, что температурочувствительный фенотип alp1-1315 не связан с прохождением определенной фазы клеточного цикла при запрещенной температуре, белок Alp1-1315 перестает выполнять свою функцию уже после 2 часов пребывания при 36oC независимо от стадии клеточного цикла. Это означает, что в клетках с мутацией в гене, кодирующем кофактор, D ab-тубулиновые гетеродимеры способны функционировать на протяжении одного клеточного цикла при 36°С.
Практическая значимость. Сбой в контроле клеточного деления приводит к патологическим событиям для клетки, таким как гибель или неконтролируемый рост. Исследование различных аспектов клеточного деления позволяет продвинуться в понимании фундаментальных механизмов, обеспечивающих правильность клеточного делениям. Кроме этого, было показано, что нарушение димеризации тубулина и недостаток микротрубочек приводит к возникновению у человека тяжелых заболеваний, таких как синдромы Sanjad-Sakati и Kenny-Caffey (Parvari et al. 2002). Поэтому исследование функции шаперонов тубулина является важной задачей, которая может иметь практическое значение для лечения подобных заболеваний.
Основные положения, выносимые на защиту:
1. Мутации в кофакторе D приводят к повышению частоты потери минихромосомы. Степень этого эффекта зависит от условий роста клеток, от нарушений функционирования кинетохора, вызванного изменением уровня СЕNP-В-подобного белка Аbp1p, а также от нормального функционирования митотического чекпойнта.
2. Генетические взаимодействия мутантов кофактора D указывают на то, что возможными партнерами кофактора D cреди белков кинетохорного комплекса являются белки Abp1 и Dis1.
3. Нарушение функции кофактора D приводит к неправильной сегрегации хромосом скорее всего из-за отсутствия нормальной метафазной конфигурации. Этот дефект может быть вызван проблемами с поддержанием метафазной структуры веретена и/или нарушениями кинетохор-микротрубочковых взаимодействий.
4. Гибель мутантов кофактора D через 4 часа после перевода клеток в условия, нарушающие работу этого белка, скорее всего, связана с тем, что при отсутствии функции кофактора D, ab-тубулиновые гетеродимеры способны функционировать на протяжении только одного клеточного цикла.
Структура диссертации. Диссертация изложена на 100 страницах машинописного текста, состоит из введения, четырех глав (главы 1 — обзора литературы, главы 2 — описания материалов и методов, главы 3 — описание экспериментальных результатов, главы 4 — обсуждения результатов), выводов и библиографического указателя, включающего 152 источников. Работа выполнена на базе Гематологического Научного Центра РАМН в лаборатории физической биохимии системы крови (зав. лабораторией проф., д. б.н. ).
Апробация работы состоялась на заседании проблемной комиссии ГНЦ РАМН “Биохимия, биофизика и реология крови” 20 марта 2008 года, а также на заседании секции “Молекулярная Биология” Ученого Совета ФГУП "ГосНИИгенетика" 13 октября 2008 года.
Материалы диссертации докладывались на конференции "От современной фундаментальной биологии к новым наукоемким технологиям" (Пущино, октябрь 2001 г.), на международной конференции “Molecular genetics of eucaryotes” (Москва, февраль 2003г.), на III-м Съезде биофизиков России (Воронеж, июнь 2004 г.), на конференции "От современной фундаментальной биологии к новым наукоемким технологиям" (Пущино, ноябрь 2002 г.).
Публикации. Материалы диссертации опубликованы в сборниках трудов 4 конференций и 2 статьи.
МАТЕРИАЛЫ И МЕТОДЫ.
Cреды и условия роста S. pombe. Все штаммы использованные в данной работе описаны в Таблице 1. Все среды и условия роста S. pombe описаны в (Moreno et al. 1991): YES (Yeast Extract with Supplements) – богатая среда; EMM (Edinburg Minimal Medium) – минимальная среда; MEA (Malt Extract with Agar) – среда для проведения скрещиваний делящихся дрожжей. Для получения твердой среды добавлялся 2% агара Difco (Detroit). Для оценки жизнеспособности клеток в среду добавляли флоксин B (сокращенно PhB), Sigma (St. Louis) в концентрации 5 мг/л, который окрашивает нежизнеспособные клетки в красный цвет. Штаммы c температурочувствительными мутациями ( такие как alp1-1315, alp1-t1) выращивали при температуре 25oС. Штаммы дикого типа, штаммы с холодочувствительными мутациями (такой как ∆dis1+) выращивали при температуре 32oС Концентрация клеток в жидкой культуре определялась посредством подсчета под микроскопом в камере Горяева.
Генетические методы.
В работе использовались стандартные генетические методы, описанные в (Moreno et al. 1991). Для получения двойных мутантов были использованы методы тетрадного анализа и метод случайных спор.
Метод случайных спор. Свежие клетки, имеющие разные типы спаривания смешивали с добавлением стерильной воды на MEA. Чашку со смешанными штаммами инкубировали 2 дня при 25oС. Через два дня образуются конъюгаты из двух клеток разного типа спаривания, которые спорулируют и превращаются в аски. Образование асков визуально контролировали под микроскопом. Далее с чашки отбирали ~ 10-50 мкл материала, ресуспендировали в 1 мл воды и инкубировали с 2u фермента глусилазы в течение 2 суток для лизиса оболочки аска. Далее споры проращивали на питательной среде на 25оС или 32оС и анализировали потомство при помощи отпечатков на разные среды и температуры.
Метод тетрадного анализа. Этот метод позволяет проследить за потомством двух конкретных клеток, что является преимуществом при получении двойных мутантов в том случае, когда их нельзя однозначно определить по фенотипу. Клетки скрещивали и получали аски, как описано в методе случайных спор. Полученные аски наносили в небольшом количестве на чашку, с богатой средой. Полные тетрады (аски, содержащие 4 споры) при помощи микроскопа с микроманипулятором (Zeicc) переносили на позиции, затем чашку инкубировали при разрешающей температуре; через 4-6 часов тетрады разваливаются на споры, после чего споры переносили на позиции в группы, соответствующие каждой тетраде. Далее споры выращивали при разрешающей температуре. Анализ потомства проводили при помощи отпечатков на разные среды и температуры.
Методы клеточной и молекулярной биологии.
Трансформация клеток S. pombe. Для трансформации плазмид pSp200, pSp200-abp1+ (предоставлены L. Clarke) в клетки S. pombe использовался “ацетатно-литиевый” метод (Moreno et al. 1991) в упрощенном варианте. Свежие клетки S. pombe, обрабатывали 0,1 M ацетата лития (Fluka) pH 5.0, ресуспендировали в том же растворе до конечного объема 100 мкл. и добавляли плазмидную ДНК и ДНК-носитель (Hering Sperm DNA (Promega). Затем инкубировали в присутствии 50% PEG
Tаблица 1. Штаммы S. pombe, использованные в работе
Штамм | Генотип | Источник |
SPW 2 | 972 h- | Лаб. коллекция |
SPW20 | leu1-32 ura4-D18 h- | Лаб. коллекция |
McI#468 | alp1-1315 h- | Эта работа |
SP26 | alp1-t1 leu1-32 ura4-D18 h- | Grishchuk et al. 1998 |
SP 88 | alp1-t1 Dmad2::ura4+ ade6-M216 leu1-32 ura4- h- | Эта работа |
SP 79 | alp1-t1 mis12:HA LEU2 leu1-32 ura4-D18 h- | Эта работа |
SPM 190 | alp1-t1 Ddis1::ura4+ leu1-32 ura4-D18 h- | Эта работа |
SPM112 | alp1-1315 leu1-32 ura4-D18 h- | Hirata et al. 1998 |
SPM 201 | alp1-1315 Dmad2::ura4+ ade6-M216 leu1-32 ura4- h- | Эта работа |
SPM 155 | alp1-1315 mis12:HA LEU2 leu1-32 ura4-D18 h- | Эта работа |
SPW 62 | mis12:HA LEU2 leu1-32 ura4-D18 h- | Goshima et al. 1999 |
SPM 122 | Dabp1::ura4+ ade6-M216 leu1-32 ura4-D18 h- | Halverson et al. 1997 |
McI#535 | Ddis1::ura4+ leu1-32 ura4-D18 h- | Nabeshima et al.1995 |
SPM 191 | Dmad2::ura4+ade6-M216 leu1-32 ura4-DS/E h- | He et al.1997 |
SPM114 | mis6-302 leu1-32 ura4-D18 h- | Takahashi et al. 1994 |
SPM 115 | mis12-537 leu1-32 ura4-D18 h+ | Takahashi et al. 1994 |
SPM 125 | mis12-537 Dabp1::ura4+ leu1-32 ura4-D18 h- | Эта работа |
SPM 70 | nda2-52 leu1-32 ura4-D18 h- | Toda et al. 1983 |
SPM 64 | nda3-311 leu1-32 ura4-D18 h- | Toda et al. 1983 |
SPM 173 | cdc25-22 leu1-32 ura4-D18 h- | Ogden and Fantes 1986 |
SPM 154 | cdc25-22 alp1-1315 leu1-32 ura4-D18 h- | Эта работа |
SPW 60 | ade6-704 leu1-32 ura4-D18 h- /pSp(cen1)-7L-sup3E/pSp200 | Halverson et al. 1997 |
SPW 61 | ade6-704 leu1-32 ura4-D18h-/ pSp(cen1)-7L-sup3E/pSp200-abp1+ | Halverson et al. 1997 |
SP 77 | alp1-t1 ade6-704 leu1-32 ura4-D18 h-/pSp(cen1)-7L - sup3E/ pSp200 | Эта работа |
SP 78 | alp1-t1 ade6-704 leu1-32 ura4-D18 h- /pSp(cen1)-7L-sup3E/ pSp200-abp1+ | Эта работа |
SPM 151 | alp1-1315 ade6-704 leu1-32 ura4-D18 h-/pSp(cen1)-7L-sup3E/ pSp200 | Эта работа |
SPM 152 | alp1-1315 ade6-704 leu1-32 ura4-D18 h- /pSp(cen1)-7L-sup3E/ pSp200-abp1+ | Эта работа |
3350 (Sigma) 14 часов. Далее отмывали в 1 мл ½YES (пополам с водой) и инкубировали в течение 20 минут при 25oС, инкубировали 2 часа, а затем высевали на селективную среду без лейцина.
Измерение частоты потери минихромосомы pSp(cen1)-7L-sup3E. Штамм с минихромосомой pSp(cen1)-7L-sup3E (SPW52) предоставлен L. Clarke, (Halverson et al. 1997). Измерение частоты потери минихромосомы производилось методом, основанном на проявлении адениновой ауксотрофности и описанном в (Hieter et al. 1985). Клетки, содержащие плазмиды, pSp200 или pSp200-abp1+, и минихромосому pSp(cen1)-7L-sup3E, растили в EMM без добавок при температуре 25ºC до концентрации 1-5×106 клеток/мл и высевали на среду YES+1/25ade (стандартная cреда YES с концентрацией аденина, пониженной в 25 раз (10 мкг/мл). Так как исходно в клетках содержится мутация ade6-704, а на минихромосоме pSp(cen1)-7L-sup3E находится ее супрессор sup3E, то при потере минихромосомы теряется и супрессор мутации ade6-704, и в клетках накапливается предшественник аденина, окрашивающий клетки без минихромосомы в красный цвет. Частота потери минихромосомы F рассчитывалась по формуле F=S/(N-R), где R — количество полностью красных колоний (ade-), S — количество колоний, красных не менее, чем наполовину, N — общее число колоний. Метод позволяет определить частоту потери минихромосомы в первом делении, так как S — это количество колоний, потерявших минихромосому как минимум в первом делении после высева.
Синхронизация клеток S. pombe в G1/Go-фазе методом азотного голодания. Синхронизация клеток в G1-фазе методом азотного голодания была выполнена как описано в (Goshima et al. 1999). Метод основан на физиологическом свойстве дрожжей размножаться митозом в богатой среде или мейозом при недостатке азота. В G1-фазе клетка анализирует пищевой статус и делает выбор по митотическому или мейотическому циклу развиваться. Поскольку штаммы, используемые в данной работе не могут менять тип спаривания, благодаря специальной мутации, то при отсутствии источника азота в среде эти клетки останавливаются в G1/Go-фазе клеточного цикла. Клетки с мутацией alp1-1315, не содержащие ауксотрофных мутаций, выращивали в жидкой среде EMM при 25ºC до концентрации 5×106 кл/мл, отмывали в EMM-N (EMM без источника азота), концентрировали центрифугированием до 2 ×107кл/мл в EMM-N. Полученную суспензию клеток инкубировали при 25ºC в течение 22 часов. После этого клетки помещали в богатую среду YES и инкубировали при 36ºC.
Процедура FACSсаn-анализа или проточной цитометрии была выполнена как описано в (Grishchuk et al. 1998). Примерно 1×107 кл/мл дрожжевых клеток, фиксировали в 70% этаноле, охлажденном до -20ºC, и хранили при 4ºC в течение нескольких дней. 15-100 мкл клеточной суспензии в 70% этаноле помещали в 1 мл 50 мM sodium citrate (Sigma) с 1 мг/мл RNAase для удаления РНК. После 2-4 часов инкубации при 37ºC, 5 мкг/мл propidium iodide (Sigma) был добавлен к клеточной суспензии для окраски ДНК. Окрашенные клетки разводили в 50 мM sodium citrate и мягко обрабатывали ультразвуком. Cодержание ДНК анализировали при помощи цитометра FACScan (Becton Dickinson, San Jose, CA). Контролем послужил гаплоидный штамм дикого типа в фазе активного роста.
Иммунофлуоресценция. Иммунофлуоресцентная покраска Mis12:HA и Sad1p, белок SPB, была выполнена как описано в (Alfa et al. 1993). Культуру клеток в log-фазе (концентрация 1-3×106 кл/мл), выращенную при 25ºC, переносили на 36ºC. Образцы брали каждые пол-часа в течение 4.5 часов и фиксировали в 4% формальдегиде 10 минут при 36ºC. В каждой точке фиксировалось 5×107 клеток. После фиксации каждый образец обрабатывался как описано (Аlfa et al. 1993) и инкубировался с первичными антителами к HA-эпитопу (Babco, разведение 1:500) и к Sad1 (kindly provided by I. Hagan, разведение 1:600). Инкубация с первичными антителами длилась 16 часов, далее следовала отмывка в буффере PEMBAL и блокировка неспецифических сайтов связывания, инкубацией в PEMBAL (40 минут). Инкубация со вторичными антителами goat anti-mouse антитела, помеченные Alexa 594, и goat anti-rabbit, помеченные Alexa 488 (Molecular probes, Inc.), (разведение 1:500) длилась 6 часов. На микроскопе Zeiss Axiophot2 с объективом 100x Plan Apo oil-immersion было посчитано более чем 300 клеток в каждой точке графика в каждом эксперименте. Фотографии сделаны при помощи камеры Cooke “SensiCam” CCD camera и обработаны Slidebook v. 3.0 software (Intelligent Imaging Inc., Denver, CO).
Для иммунофлуоресцентного окрашивания микротрубочек клетки фиксировали метанолом при -20ºC в течение 4-8 минут. Иммунофлуоресцентная покраска микротрубочек была выполнена, как описано у (Sawin and Nurse 1998). Образцы обрабатывали ферментами zymolyase (0.9 мг/мл) и lysing enzymes (0.6 мг/мл) в течение 20 минут для удаления клеточной стенки. Для окраски использовали антитела к a-тубулину TAT1 (kindly provided by Keith Gull, University of Manchester Institute of Science and Technology, U. K.) в разведении 1:200 (экспозиция 17 часов), и вторичные goat anti-mouse антитела, помеченные Alexa 488 (Molecular probes, Inc.) в разведении 1:400 (экспозиция 24 часа). На микроскопе Leica DM LA с объективом 100x Plan Apo oil-immersion было посчитано более чем 300 клеток в каждой точке графика в каждом эксперименте. Фотографии сделаны при помощи камеры Roper Scientific Coolsnap FX camera и обработаны ImageJ v. 1.34s program (fusion Complex Wavelets method).
Для окрашивания ДНК и септума в клетках использовали флуоресцентные красители DAPI (4,6-diamidino-2-phenylindole dihydrochloride, Sigma) и Calcofluor white M2R (Sigma). Клетки фиксировали в 4% формальдегиде 40 минут или в охлажденном до -20оС этаноле, как для FACScan анализа (см. выше).
РЕЗУЛЬТАТЫ И ОБСУЖДЕНИЕ
Часть I Сегрегация хромосом в клетках делящихся дрожжей с мутациями кофактора D.
Стабильность минихромосомы в мутантах кофактора D зависит от условий роста клеток.
У почкующихся дрожжей S. cerevisiae кофактор D не является жизненно необходимым, но мутации в соответствующем гене приводят к гиперчувствительности к веществам, дестабилизирующим микротрубочки, и к повышенной частоте потери минихромосомы (Hoyt et al. 1990; Stearns et al. 1990). Оба alp1+ мутанта имеют умеренную чувствительность к деполимеризатору микротрубочек TBZ относительно мутантной аллели nda2+, жизненно необходимого гена, кодирующего α-тубулин. При разрешающей температуре nda2-52 клетки не способны расти в 3 мкг/мл TBZ (Umesono et al. 1983), в то время как alp1ts клетки способны формировать колонии, если концентрация TBZ ниже 15 мкг/мл (клетки S. pombe дикого типа формируют колонии при концентрациях TBZ ниже 20 мкг/мл).
Чтобы оценить, ведут ли мутации alp1-1315 и alp1-t1 в гене alp1+ к повышению частоты потери хромосом при разрешающей температуре (повышенная частота потери минихромосомы является признаком наличия дефектов сегрегации хромосом) была определена частота потери минихромосомы в клетках с мутациями кофактора D. Штаммы с мутациями кофактора D приводят к умеренному увеличению частоты потери минихромосомы, когда растут на минимальной среде при 25ºC (Рис. 1A).
|

Рис. 1 Частота потери минихромосомы в клетках с мутациями кофактора D зависит от условий роста и присутствия гена mad2+. A. Частота потери минихромосомы, определенная для клеток дикого типа (SPW 60), alp1-1315 (SPM 151), и alp1-t1 (SP 77). Клетки высевали на 25ºC на богатую среду (YES) с пониженной концентрацией аденина (10 мкг/мл) и минимальную среду (EMM), содержащую 10 мкг/мл аденина и 250 мкг/мл урацила. B. Клетки Dmad2 (SPM 191), alp1-1315 (SPM 192), alp1-t1 (SP 27) и двойных мутантов Dmad2 alp1-1315 (SPM 201) и Dmad2 alp1- tsm1 (SP 88) инкубировали при 25ºС пять дней на YES и на EMM с аденином, лейцином и урацилом.
Частота потери минихромосомы в клетках alp1-1315 в 7.5 раз выше, а в клетках с мутацией alp1-t1 только в 2 раза выше, чем в клетках дикого типа, а в клетках дикого типа частота потери минихромосомы статистически не отличается на обеих средах. Частота потери минихромосомы в клетках alp1ts сильно возрастает, если клетки были высеяны на богатую среду: alp1-1315 клетки показали увеличение в 200 раз относительно контроля (Рис. 1A ), а в клетках с мутацией alp1-t1, выросших на YES, каждая колония содержала красный сектор, что указывает на потерю минихромосомы в первом же после высева делении (Рис.1A).Таким образом, частота потери минихромосомы в клетках с мутациями в гене, кодирующем кофактор D, зависит от среды, на которой растут клетки.
Рост клеток alp1-t1 на богатой среде контролируется белками митотического контроля (чекпойнта).
В настоящее время не определено, какой конкретно компонент среды YES ответственен за увеличение частоты потери минихромосомы в клетках с мутациями в гене, кодирующем кофактор D, однако было обнаружено, что рост клеток с мутацией alp1-t1 на среде YES зависит от присутствия гена mad2+, кодирующего компонент митотического чекпойнта (He et al. 1997). Двойные мутанты между клетками, несущими мутации alp1ts и Dmad2 были сконструированы в присутствии плазмиды с копией гена mad2+ дикого типа (любезно предоставленной S. Sazer) методом случайных спор (cм. Материалы и Методы). Когда эта плазмида утрачивалась двойными мутантами на минимальной неселективной среде, полученные штаммы делились и росли при разрешающей температуре, но alp1-t1 Dmad2 клетки не могли расти на богатой среде YES (Рис.1B). Под микроскопом в этой культуре было обнаружено много клеток с неправильно разделенной ДНК, что означает летальность и, по-видимому, является результатом неправильно прошедшего митоза. Выживаемость двойных мутантов alp1-t1 Δmad1, alp1-t1 Δmad3 и alp1-t1 Δbub3 на среде YES тоже оказалась сниженной (показано ). Рост клеток на средах разного типа, вероятно, влияет и на продолжительность различных стадий клеточного цикла и на скорость метаболических процессов. Однако специфичные пути, которые требуют присутствия выше названных генов митотического чекпойнта и ответственные за наблюдаемые различия, еще не известны. Этот эффект специфичен для mad1+, mad2+, mad3+, bub3+ , так как двойные мутанты между alp1-t1 и Δbub1 (Bernard et al. 1998) или cdc16-116 (в делящихся дрожжах гомолог BUB2 (Fankhauser et al. 1993)) растут при 25ºC независимо от типа среды (показано ). Cпоры alp1-t1 Dmph1 (He et al. 1998) не дали единичных колоний на обоих типах среды. Таким образом, Mph1p, который функционирует раньше Mad2p в пути митотического чекпойнта (He et al. 1998), жизненно необходим для роста alp1-t1 клеток при 25oC.
Неравная сегрегация хромосом в клетках с мутациями в гене, кодирующем кофактор D, сопровождается отсутствием метафазы в митозе.
Из опубликованных данных известно, что обе мутантные аллели alp1ts кофактора D имеют меньше микротрубочек при запрещающей температуре (36oC) (Grishchuk et al. 1998; Hirata et al. 1998). Тем не менее, после входа в митоз при 36ºC в существенной части клеток alp1-t1 после небольшой задержки происходит удлинение веретена деления и сегрегация хромосом (Grishchuk et al. 1998). Однако разделение масс ДНК при этом часто происходит неравным образом. Для подробного исследования сегрегации хромосом в клетках с мутациями в гене, кодирующем кофактор D, была использована иммунофлуоресценция, чтобы визуализировать ранние стадии неправильного деления (Рис.2). Контрольная асинхронная культура дикого типа содержала меньше чем 15% клеток с двумя разошедшимися полюсами в любой момент времени (Рис.2A). При этом кинетохоры были либо на линии между полюсами (прометафаза/метафаза, Рис.2D, панель b) либо присоединены к полюсам (анафаза, Рис.2D, панель c). В культурах клеток с мутациями в гене alp1+ после переноса на 36ºC стали накапливаться клетки с двумя не разошедшимися полюсами и продолжающими конденсироваться хромасомами (Рис.2D, панель d). На этой стадии примерно в ~11% клеток с мутацией alp1-1315 и в ~3 % клеток с мутацией alp1-t1 хотя бы один из трёх кинетохоров терял прикрепление к полюсу и предположительно к микротрубочке веретена деления (Рис.2D, панель e). Примерно после ~ 30-60 минут полюса начали расходиться (Рис. 2B и C), хотя и редко на длину анафазного веретена, как в контрольной культуре дикого типа. В культурах клеток с мутациями alp1-1315 и alp1-t1 не было обнаружено ни одной клетки, в которой кинетохоры были бы на линии между полюсами, даже когда расстояние между полюсами было мало как на (Рис.2D, панель b). В большинстве клеток с малым расстоянием между полюсами кинетохоры были присоединены к разошедшимся полюсам (Рис.2D, панели f - h). В большинстве клеток с малым расстоянием между полюсами кинетохоры были присоединены к разошедшимся полюсам (Рис.2D, панели f - h). Иногда один из трёх кинетохоров оказывался не связанным с полюсом, но такая конфигурация, кажется неправильной, так как оторвавшийся кинетохор располагался далеко от линии веретена деления (Рис.2D, панель i).
Основываясь на интенсивности кинетохор-ассоциированных сигналов в клетках с разошедшимися полюсами (Рис.2D, панели f – i), было оценено, что примерно в ~ 40% клеток с мутацией alp1-1315 и в ~ 30% клеток с мутацией alp1-t1 хромасомы сегрегируют неравным образом (Рис.2E). И хотя в клетках с мутациями в гене alp1+ хромосомы растягиваются как в анафазе, это происходит, минуя стадии прометафазы и метафазы. То есть хромосомы в этих клетках не собираются в метафазную пластинку и не претерпевают прометафазных осцилляций (конгрессии), которые происходят в культуре дикого типа на стадии, когда кинетохоры находятся на линии между полюсами (Рис.2D, панель b). Так как на молекулярном уровне кинетохор-микротрубочковое взаимодействие во время биориентирования
|
|
|
|

Рис. 2 Сегрегация хромосом в асинхронных культурах при 36˚C. Контрольные клетки (панель A, SPW 62), alp1-1315 (панель B, SPM 155) и alp1-t1 (панель C, SP 79) клетки инкубировали при 25ºC в YES, затем перенесли на 36ºC в точке 0 часов. Все категории на каждой панели A-C вместе с соответствующим процентом интерфазных клеток (не показано) составляют 100%. Для каждой точки было посчитано не менее 300 клеток не менее чем в двух независимых экспериментах. D. Фотографии хромосом (окрашенных DAPI), полюсов (окрашенных анти-Sad1 антителами), кинетохоров (окрашенных анти-HA антителами для визуализации Mis12p), и фото со всеми тремя сигналами (Merge). На фото представлены характерные фенотипы клеток дикого типа и alp1-1315, проинкубированных 3 - 5 часов при 36ºC. Конфигурации, показанные на панелях a – c, это нормальная последовательность митотических стадий в клетках дикого типа. Конфигурации, показанные на остальных панелях, были найдены только в клетках с мутациями. a – удвоенные полюса рядом друг с другом и со всеми кинетохорами; b - ранний митоз (нормальная прометафазная/метафазная конфигурация): полюса разошлись, кинетохоры расположились в линию между ними; c - анафазная конфигурация: полюса продолжают расходится, при обоих полюсах примерно равные кинетохорные сигналы; d - полюса рядом друг с другом и со всеми кинетохорами, но хромосомы гиперконденсированы; e – некоторые кинетохоры гиперконденсированных хромосом рядом с неразделенными полюсами, но по-крайней мере один кинетохор вне полюса; на панелях f – i конфигурации с разошедшимися полюсами SPBs: f, g – примерно равные кинетохорные сигналы при каждом полюсе; h – кинетохоры распределены между полюсами неравным образом; i – видны все три кинетохора, но только два из них на разошедшихся полюсах. E. Диаграмма показывает процент клеток с разошедшимися полюсами с равной (панели f, g) и наравной (панели h) сегрегацией кинетохоров.
кинетохоров изучено недостаточно (reviewed in Maiato et al. 2004; McIntosh et al. 2002), то трудно сказать, какой аспект этого высокодинамичного процесса нарушен. Так как рост на богатой среде клеток alp1-t1 зависит от присутствия Маd1, Mad2, Mad3, Bub3-зависимого чекпойнта (Hardwick et al. 1996; Lew and Burke 2003), но не Bub1p, то это может означать, что в клетках alp1-t1 прикрепление кинетохора к микротрубочкам во время прометафазы затруднено или недостаточно, но так как веретено строится и кинетохоры прикрепляются к нему, то по-видимому, нормальное натяжение в конце концов устанавливается.
Мутации в гене, кодирующем кофактор D, чувствительны к повышению уровня экспрессии CENP-B-подобного белка Abp1p.
Результаты, описанные выше, могут означать, что митотические дефекты в клетках с мутациями в гене alp1+, в большей степени обусловлены неправильной сегрегацией хромосом из-за дефектов в закреплении микротрубочек на кинетохоре, чем вследствие ошибок в формировании веретена деления. Это заключение подтверждается наличием сильных генетических взаимодействий между alp1-t1 и abp1+ (Murakami et al. 1996). Abp1p это один из трех гомологов в S. pombe центромер-связывающего белка CENP-B (Murakami et al. 1996). Было показано , что сверхэкспрессия abp1+ улучшает рост клеток с мутацией alp1-t1, но не alp1-1315 на минимальной среде при 36°C. А делеция гена abp1+ приводит к гибели alp1-t1, но не alp1-1315 клеток при разрешающей температуре.
Известно, что и удаление гена abp1+ и его сверхэкспрессия нарушают сегрегацию хромосом (Baum and Clarke 2000; Halverson et al. 1997; Irelan et al. 2001), в то же время увеличение уровня abp1+ способствует росту клеток с alp1-t1. Чтобы подробнее
| Рис.3 Влияние сверхэкспрессии abp1+ на частоту потери минихромосомы в клетках с мутациями кофактора D. На диаграмме представлено отношение значения Fpabp1+ - частоты потери минихромосомы для клеток, содержащих плазмиду с геном abp1+ (pabp1+) к Fp - значению частоты потери минихромосомы для клеток с контрольной плазмидой (p). |
исследовать это взаимодействие была измерена частота потери минихромосомы в клетках с мутациями alp1-t1 и alp1-1315 при повышенном и нормальном уровне экспрессии abp1+ (Рис.3). На рисунке 3 показано среднее увеличение частоты потери минихромосомы в клетках, несущих многокопийную плазмиду с геном abp1+ относительно частоты потери минихромосомы в клетках, несущих контрольную плазмиду без гена abp1+. В соответствии с опубликованными результатами в (Halverson et al. 1997), было обнаружено, что сверхэкспрессия Abp1p в контрольных клетках дикого типа ведет к увеличению частоты потери минихромосомы примерно в ~10 раз на богатой среде YES. На минимальной среде EMM c cелекцией на плазмиду минихромосома теряется в 100 раз чаще (Рис.3). В отличие от cреды YES, в минимальной среде ЕММ отсутствует лейцин, и на ней могут формировать колонии только те клетки, которые имеют плазмиду. Однако этот факт не может объяснить разницу в 10 раз в частоте потери минихромосомы, так как было проверено, что перед высевом плазмиду теряет только ~50% клеток. В клетках с мутацией alp1-t1 не было различий в частоте потери минихромосомы в зависимости от уровня экспрессии abp1+ на YES, но было обнаружено увеличение частоты потери минихромосомы почти в 700 раз на ЕММ. Частота потери минихромосомы в клетках с мутацией alp1-1315 оказалась более устойчива к сверхэкспрессии Abp1p, чем клетки дикого типа. Не было обнаружено никакого изменения частоты потери минихромосомы на богатой среде, и увеличение частоты потери минихромосомы примерно в ~50 раз на минимально среде (Таблица 2, Рис.3).
Генетические взаимодействия между компонентами кинетохора и веретена деления предполагают их существенную роль в установлении оптимального соединения кинетохора с микротрубочкой.
Клетки с мутацией alp1-t1 характеризуются сложным набором генетических взаимодействий с различными генами, кодирующими белки, задействованные в митозе, такие как компоненты Комплекса Инициирующего Анафазу (Anaphase Promoting Complex (APC)), протеасомы и тубулины (Grishchuk et al. 1998). Но не было найдено генетических взаимодействий между alp1-t1 и компонентами кинетохора, mis12-537 и mis6-302 (Grishchuk et al. 1998). Клетки с делецией abp1+ генетически не взаимодействуют ни с компонентами APC (nuc2-663 и cut4-533), ни с компонентами протеасомы (mts2-1 и mts3-1), ни с nda3-311, мутацией в гене, кодирующем b-тубулин, но не жизнеспособна в сочетании с nda2-52, мутацией в гене, кодирующем a-тубулин (показано и L. Trihn). Также Dabp1 слабо супрессирует температурную чувствительность клеток с мутацией mis12-537, но не mis6-302 (mis12+ и mis6+ - компоненты кинетохора). Это наблюдение особенно интересно тем, что мутация mis12-537 супрессирует холодочувствительность, обусловленную отсутствием

Рис.4 Анализ генетических взаимодействий и чувствительности к TSA. A. Dabp1 частично супрессирует температурную чувствительность mis12-537. На фото показывают mis12 (SPM 115) и mis12 Dabp1 (SPM 125) клетки, выращенные на YES 4-5 дней при 36°C (сверху) и 25°C (снизу) (сделано П. Мардановым). Медленный рост двойного мутанта обусловлен присутствием мутации Dabp1 (Halverson et al.1997). B. alp1-t1 супрессирует холодочувствительность Ddis1. Дикий тип (SPW 20), alp1-t1 (SP26), Ddis1 (McI#535) и Ddis1 alp1-t1 (два незевисимо изолированных штамма, имеющих идентичный фенотип как у SPM 190). Клетки были расстрикованы до единичных колоний на YES, чашки инкубировали при обозначенных температурах 3-6 дней. Такие же результаты были получены с мутацией dis1cs (не показано; Ohkura et al. 1988). C. Ddis1 гиперчувствителен к TSA. Дикий тип (SPW 20) и Ddis1 (McI#535) клетки были расстрикованы до единичных колоний на YES с добавлением 0.2% DMSO (сверху) или с 0.2% DMSO и TSA (10 mg/ml) (снизу) и проинкубированы 3 дня при 32°C.
кинетохор - и микротрубочко-связывающего белка Dis1p (Pис.4) (Decottignies et al. 2001; Kobayashi et al. 2007; Nabeshima et al. 1995; Nakaseko et al. 2001).
Но генетических взаимодействий между Ddis1 и Dabp1 найдено не было (показано ). В данной работе было проверено наличие генетических взаимодействий между Ddis1 и мутациями в гене, кодирующем кофактор D. Оказалось, что холодочувствительная мутация Ddis1 (а также и другая мутация dis1cs) супрессирует alp1-t1, но не alp1-1315. Клетки двойного мутанта аlp1-t1 Ddis1 были температурочувствительны, как аlp1-t1 (не росли при 36ºC), но могли расти при 22ºC неотличимо от клеток с мутацией аlp1-t1, что означает супрессию Ddis1 (Рис.4B).
Мутация alp1-t1 разрушает нормальное функционирование митотических микротрубочек, и это спасает Ddis1: кажется правдоподобным, что нарушения сегрегации хромосом в Ddis1 могут компенсироваться за счет дестабилизации микротрубочек. Было проверено, нельзя ли супрессировать холодочувствительность Ddis1, если добавить в среду химический деполимеризатор микротрубочек - TBZ. Однако оказалось, что TBZ в концентрациях (1 – 20 мкг/мл) не супрессирует холодочувствительность клеток с мутацией Ddis1. Это означает, что взаимодействие между мутациями в генах, кодирующих кофактор D и Dis1p, специфично и может влиять на изменения в структуре кинетохора, обусловленные отсутствием Dis1p. Это заключение частично базируется на том, что было обнаружено, что рост клеток с мутацией Ddis1 при разрешающей температуре полностью блокируется добавлением 10 мкг/мл TSA (Рис.4C), специфичным ингибитором гистоновых деацетилаз, который влияет на общую структуру центромеры (Ekwall et al. 1997). Ни одна из мутаций Dabp1, alp1-1315, alp1-t1, nda2-52, nda3-311, mis6-302, mis12-537 не чувствительны к этому веществу.
Тот факт, что abp1+ ген является высококопийным супрессором мутации alp1-t1, также как и кофактор E, позволяет предположить, что уменьшение концентрации димеров в бòльшей степени влияет на кинетохор-микротрубочковое взаимодействие, чем на расхождение полюсов и формирование веретена деления. Это заключение подтверждает наличие аллель-специфичной синтетической летальности между кофактором D и Dabp1, в то время как взаимодействий с другими постоянными компонентами кинетохора, Mis6p and Mis12p, найдено не было. В клетках дикого типа и сверхэкспрессия abp1+ гена и его делеция приводят к примерно одинаковому увеличению частоты потери минихромосомы (Baum and Clarke 2000; Halverson et al. 1997). Тем поразительнее тот факт, что мутация кофактора D, имеющая дефекты в сегрегации хромосом, может быть частично супрессирована Abp1p. А также тот факт, что другая мутантная аллель кофактора D, alp1-1315 более устойчива к перепроизводству Abp1p, чем ген дикого типа. Таким образом, несмотря на то, что избыток Abp1p вредит нормальным клеткам, он может частично компенсировать дефекты, обусловленные мутациями кофактора D.
Часть II Тубулиновые димеры при нарушении функции кофактора D остаются функциональными в течение одного клеточного цикла.
Клетки с мутацией alp1-1315 гибнут в первом митозе при 36°С после синхронизации в G1-фазе.
|
|
|
| ||||||||||||||||
![]()
|
![]()
|
![]()
|
Рис.5 Выживаемость и цитология клеток с мутацией alp1-1315 при 36ºC после синхронизации в G1-фазе. Клетки дикого типа (SPW 2) и alp1-1315 (SPM 233), предварительно остановленные в G1-фазе при помощи азотного голодания при 25ºC, перенесли в богатую среду YES на 36ºC (0 часов). Анализировали концентрацию клеток (A) и их выживаемость (B). Выживаемость клеток была получена путем высевания клеток в каждой точке на среду YES, 25oC. (C) и (D) Цитология клеток дикого типа (C) и alp1-1315 (D). Все категории на панелях C, D в сумме с соответствующем процентом интерфазных клеток (не показано) составляют 100%. По крайней мере по 300 клеток было проанализировано в каждой точке в 4 независимых экспериментах. После 4-5 часов инкубации (время первого митоза), в культуре клеток alp1-1315 стали накапливаться неправильно поделившиеся клетки. (E) и (F) - содержание ДНК, определенное на FACScan в 0-10 часов. Контроль - это клетки дикого типа (SPW 20) в фазе активного роста (log-фазе).
Выживаемость в культуре клеток с мутацией alp1-1315 начала падать уже после 1 часа роста при 36oС (Рис.5B). Анализ цитологии клеток с мутацией alp1-1315 показал, что после первого же деления в культуре стали накапливаться неправильно поделившиеся клетки, то есть неравным образом сегрегировавшие хромосомы (Рис.5D). Эти результаты могут означать, что Alp1 имеет дефект в G1- или S-фазе клеточного цикла.
Клетки с мутацией alp1-1315 не имеют дефектов в прохождении S-фазы.
Для того чтобы определить становится ли дефектным Alp1-1315 после G1- или после S-фазы клеточного цикла при 36°C, был выполнен анализ при помощи проточной цитометрии (FACScan анализ) клеток с мутацией alp1-1315, предварительно синхронизованных в G1 и затем перенесенных на 36°C. FACScan анализ показал, что репликация ДНК произошла через 3 часа после переноса на 36°C и освобождения после азотного голодания, то есть в то же время, что и в контрольной культуре дикого типа (Рис.5, панели E и F). Прохождение через S-фазу в культуре клеток с дефектным кофактором D выглядит неотличимо от дикого типа. Нарушения в распределении и содержании хромосомальной ДНК появляются после первого митоза при 36°С (Рис.5F). Следовательно, клетки alp1-1315 погибают после первого же митоза, если предварительно они были синхронизованы в G1-фазе, и после второго митоза, если предварительно они были синхронизованы в G2-фазе. Подобное поведение демонстрируют клетки с мутациями в генах, имеющих жизненно важную функцию в G1-фазе, например, mis6-306 и mis4-242 (Furuya et al. 1998; Saitoh et al. 1997). Следовательно, эти результаты показывают, что Alp1 может действовать в G1-фазе, и невыполнение его функции в G1-фазе приводит к неравной сегрегации хромосом в последующем митозе. Но следует заметить, что после синхронизации в G2-фазе, клетки с мутацией alp1-1315 погибают во втором митозе после 4 часов при 36°С; после синхронизации в G1/G0-фазе, клетки с мутацией alp1-1315 погибают в первом митозе тоже после пяти часов инкубации при 36°С. Таким образом, возможна альтернативная гипотеза: если время инактивации Alp1-1315 и последующей диссоциации тубулиновых димеров составляет 2-4 часа, то клетки с мутацией alp1-1315 будут умирать после четырех часов независимо от того, в какой фазе клеточного цикла они предварительно были синхронизованы. Следовательно, вышеописанный фенотип может быть обусловлен диссоциацией тубулиновых димеров при 36°С до митоза вследствие отсутствия кофактора D, способного сворачивать тубулиновые димеры, а не ошибкой в выполнении какой-либо функции в G1-фазе. Время диссоциации тубулиновых димеров в S. pombe не известно, но димеры млекопитающих in vitro диссоциируют медленно с Tdis~20 часов (Сaplow and Fee 2002). То есть по этой оценке, они могут существовать более 5 часов.
Микротрубочки в клетках с мутацией alp1-1315 становятся сильно поврежденными через 3 часа инкубации при 36○C независимо от прохождения G1-фазы.
Для выбора между двумя гипотезами, описанными выше, мы оценили степень повреждения микротрубочек в клетках cdc25-22 alp1-1315 с использованием иммунофлуоресцентного окрашивания микротрубочек в фиксированных клетках при помощи антител к a-тубулину TAT-1(см. Материалы и методы).
В течение первых двух часов инкубации при 36°С в культурах cdc25-22 alp1-1315 и alp1-1315 почти все клетки имели полный набор довольно длинных микротрубочек, после двух часов при 36°С число и длина микротрубочек в клетке в культурах cdc25-22
|
|
|
|
Рис.6 Состояние микротрубочек в клетках cdc25-22 alp1-1315 во время cdc25-22-зависимой блокировки клеточного деления. Культуры клеток в фазе активного роста сdc25-22 (SPM 173), alp1-1315 (SPM 112), cdc25-22 alp1-1315 (SPM 154), выращенные на YES при 25oC, были перенесены на 36oC (точка 0 часов). (A), (B) На графиках нанесен процент клеток, имеющих 5-8 цитоплазматических микротрубочек (Неповрежденные), процент клеток с редуцированными микротрубочками по длине и по количеству (Редуцированные), процент клеток, в которых отсутствует покраска на тубулин (Отсутствуют) в культурах cdc25-22 и alp1-1315 (A); и в cdc25-22 alp1-1315 (B). Для каждой точки по крайней мере 300 клеток было проанализировано не менее, чем в трех независимых экспериментах. (C) Фотографии структур микротрубочек после 10 часов при 36oC.
alp1-1315 и alp1-1315 быстро сокращалась. Через три часа в культурах cdc25-22 alp1-1315 и alp1-1315 не было найдено клеток, содержащих неповрежденные микротрубочки (Рис.6, панели A и B). После пяти часов инкубации при 36°С, как и в предыдущем эксперименте клетки в культуре cdc25-22 alp1-1315 начали ветвиться (Рис.6C). В целом после трех часов состояние микротрубочек в культурах cdc25-22 alp1-1315 и alp1-1315 менялось медленно (Рис.6, панели A и B). Хотя в культуре cdc25-22 alp1-1315 довольно длинные куски цитоплазматических микротрубочек были видны в 50% клеток даже после 10 часов инкубации при 36°С (Рис.6D, правая панель). Эти результаты хорошо согласуются с предыдущими исследованиями цитоскелета в alp1-t1 и alp1-1315 при 36°С (Grishchuk et al. 1998; Hirata et al. 1998). Из полученных результатов можно заключить, что: 1) Alp1-1315 инактивируется и перестает формировать димеры уже через два часа инкубации при 36°С независимо от прохождения G1-фазы; 2) микротрубочки в клетках с мутацией alp1-1315 становятся сильно поврежденными через 3 часа инкубации при 36○C, то есть запаса тубулиновых димеров при нарушении функции кофактора D хватает только на один клеточный цикл; 3) без кофактора D, микротрубочки могут существовать в клетке, но их недостаточно для успешного прохождения через митоз после четырех часов при 36oC. Что и приводит к гибели клеток в ближайшем митозе и/или к ветвлению в сdc25-22 alp1-1315. Известно, что низкая концентрация димеров in vitro приводит к уменьшению скорости роста микротрубочек, увеличению частоты катастроф и уменьшению средней длины микротрубочек (Walker et al. 1988). Это хорошо согласуется с вышеприведенными результатами. Эксперименты с покраской микротрубочек позволяют грубо оценить in vivo время функционирования димеров тубулина. В клетках с мутацией в гене, кодирующем кофактор D, при 36oC ab-тубулиновые гетеродимеры способны функционировать на протяжении одного клеточного цикла.
Часть III Клетки cdc25-22 alp1-1315, освобожденные после cdc25-22-зависимой блокировки митотического деления, имеют примерно часовую задержку в инициации митоза.
Появление на полюсе Plo1-GFP задерживается и имеет медленную кинетику в клетках cdc25-22 alp1-1315, освобожденных после cdc25-22-зависимой блокировки митотического деления.
Результаты, полученные выше, говорят о том, что у клеток cdc25-22 alp1-1315, заканчиваются функциональные димеры тубулина, но при этом выживаемость клеток во время cdc25-22-зависимой блокировки клеточного деления при помощи мутации cdc25-22 остается высокой в течение более чем 6 часов (данные не показаны). Это означает, что после переноса на 25°С у клеток должна быть задержка либо перед митозом, либо в митозе, что даст им возможность пополнить запас димеров. Было исследовано прохождение через митоз клеток cdc25-22 alp1-1315 и кинетика появления на полюсе Plo1 киназы (самое раннее событие митоза) (Bähler et al. 1998; Mulvihill et al. 1999). В литературе описано, что для инициации митоза после блокировки клеточного цикла при помощи cdc25-22 и появления на полюсе Plo1 нужны микротрубочки и/или димеры тубулина (Alfa et al. 1990; Mulvihill and Hyams 2002). Нами было показано, что в клетках cdc25-22 alp1-1315, во-первых, задерживается вход в митоз примерно на 30 минут, а, во-вторых, все события митоза протекают гораздо медленнее, чем у клеток cdc25-22 (данные не приведены). Это означает, что инициация митоза в отсутствие микротрубочек и, тубулиновых димеров затруднен, что замедляет рост активности Cdc25 и продвижение митоза (Mulvihill et al. 1999). Эти результаты и указывают на то, что для инициации митоза после снятия cdc25-22-зависимой блокировки клеточного цикла важны либо тубулиновые димеры, либо микротрубочки.
В клетках cdc25-22 alp1-1315, освобожденных после cdc25-22-зависимой блокировки митотического деления, не наблюдается изменений ни в количестве, ни в длине микротрубочек, но есть изменения в их яркости.
Для того чтобы разобраться, что важно для инициации митоза после снятия cdc25-22-зависимой блокировки клеточного цикла - микротрубочки или тубулиновые димеры, было исследовано построение веретена в клетках cdc25-22 alp1-1315 при помощи окраски антителами к тубулину (данные не показаны). Если дело в микротрубочках, то перед инициацией митоза должен быть момент, когда произойдут изменения в структурах микротрубочек, например, они увеличат свою длину и/или количество. Покраска антителами к тубулину, показала, что сначала в клетках видны остатки цитоплазматических микротрубочек. Яркость цитоплазматических трубочек сначала падает что, по-видимому, обусловлено распадом цитоплазматических микротрубочек перед митозом, а потом возрастает (данные не показаны). Причиной возрастания яркости скорее всего является появление новых димеров. Таким образом, в клетках cdc25-22 alp1-1315 после снятия cdc25-22-зависимой блокировки клеточного цикла не наблюдается изменений ни в количестве, ни в длине микротрубочек, но есть изменения в их яркости. Эти результаты свидетельствуют в пользу гипотезы о том, что для инициации митоза после снятия cdc25-22-зависимой блокировки клеточного цикла важно присутствие тубулиновых димеров.
ВЫВОДЫ
1. Кофактор D необходим для правильной сегрегации хромосом, и, возможно, имеет дополнительную функцию, связанную с установлением оптимального соединения кинетохора с микротрубочкой.
2. Возможными партнерами кофактора D cреди белков кинетохорного комплекса являются белки Abp1 и Dis1.
3. Причиной гибели клеток с мутацией кофактора D alp1-1315 после переноса на 36oC во втором клеточном делении (через 4-5 часов) является исчезновение неповрежденных микротрубочек (через 3 часа) вследствие инактивации мутантного белка Alp1-1315 (через 2 часа).
4. ab-тубулиновые гетеродимеры при нарушении функции кофактора D способны функционировать на протяжении одного клеточного цикла.
Cписок работ, опубликованных по теме диссертации:
1. C. и (2004) Влияние сверхэкспрессии ДНК-связывающего белка гетерохроматина Abp1p на частоту потери минихромосомы и рост клеток Schizosaccharomyces pombe с мутациями гена, кодирующего кофактор D. Генетика, том 40, № 1, с. 1-11.
2. Fedyanina O. S., P. V. Mardanov, E. M. Tokareva, J. R. McIntosh and E. L. Grishchuk (2006) Chromosome segregation in fission yeast with mutations in the tubulin folding cofactor D. Curr Genet, 50: 281-294.
3. , и (2001) Влияние переэкспрессии Abp1p CENP-B-подобного белка S. pombe на частоту потери минихромосомы в мутантах кофактора D. Труды конференции “От современной науки к новым наукоемким технологиям” Пущино, 24-26 октября, c. 104.
4. , и (2002) Исследование фенотипа и генетических взаимодействий мутантов кофактора D S. pombe. Труды конференции “От современной науки к новым наукоемким технологиям” Пущино, 11-14 ноября, c. 137.
5. Fedyanina O. S., Georgiev P. G. and E. L. Grishchuk (2003) Determination of the execution point of mutant allele of the S. pombe gene, encoding tubulin-folding cofactor D. International conference “Molecular genetics of eucaryotes”, Москва, 4-7 February, c. 21.
6. , и (2004) Анализ генетических взаимодействий мутантов кофактора D S. pombe c различными мутантными аллелями МАР-белка Dis1. Материалы III Съезда биофизиков России, Воронеж, 24-29 июня, т.2, с. 800-801.

















